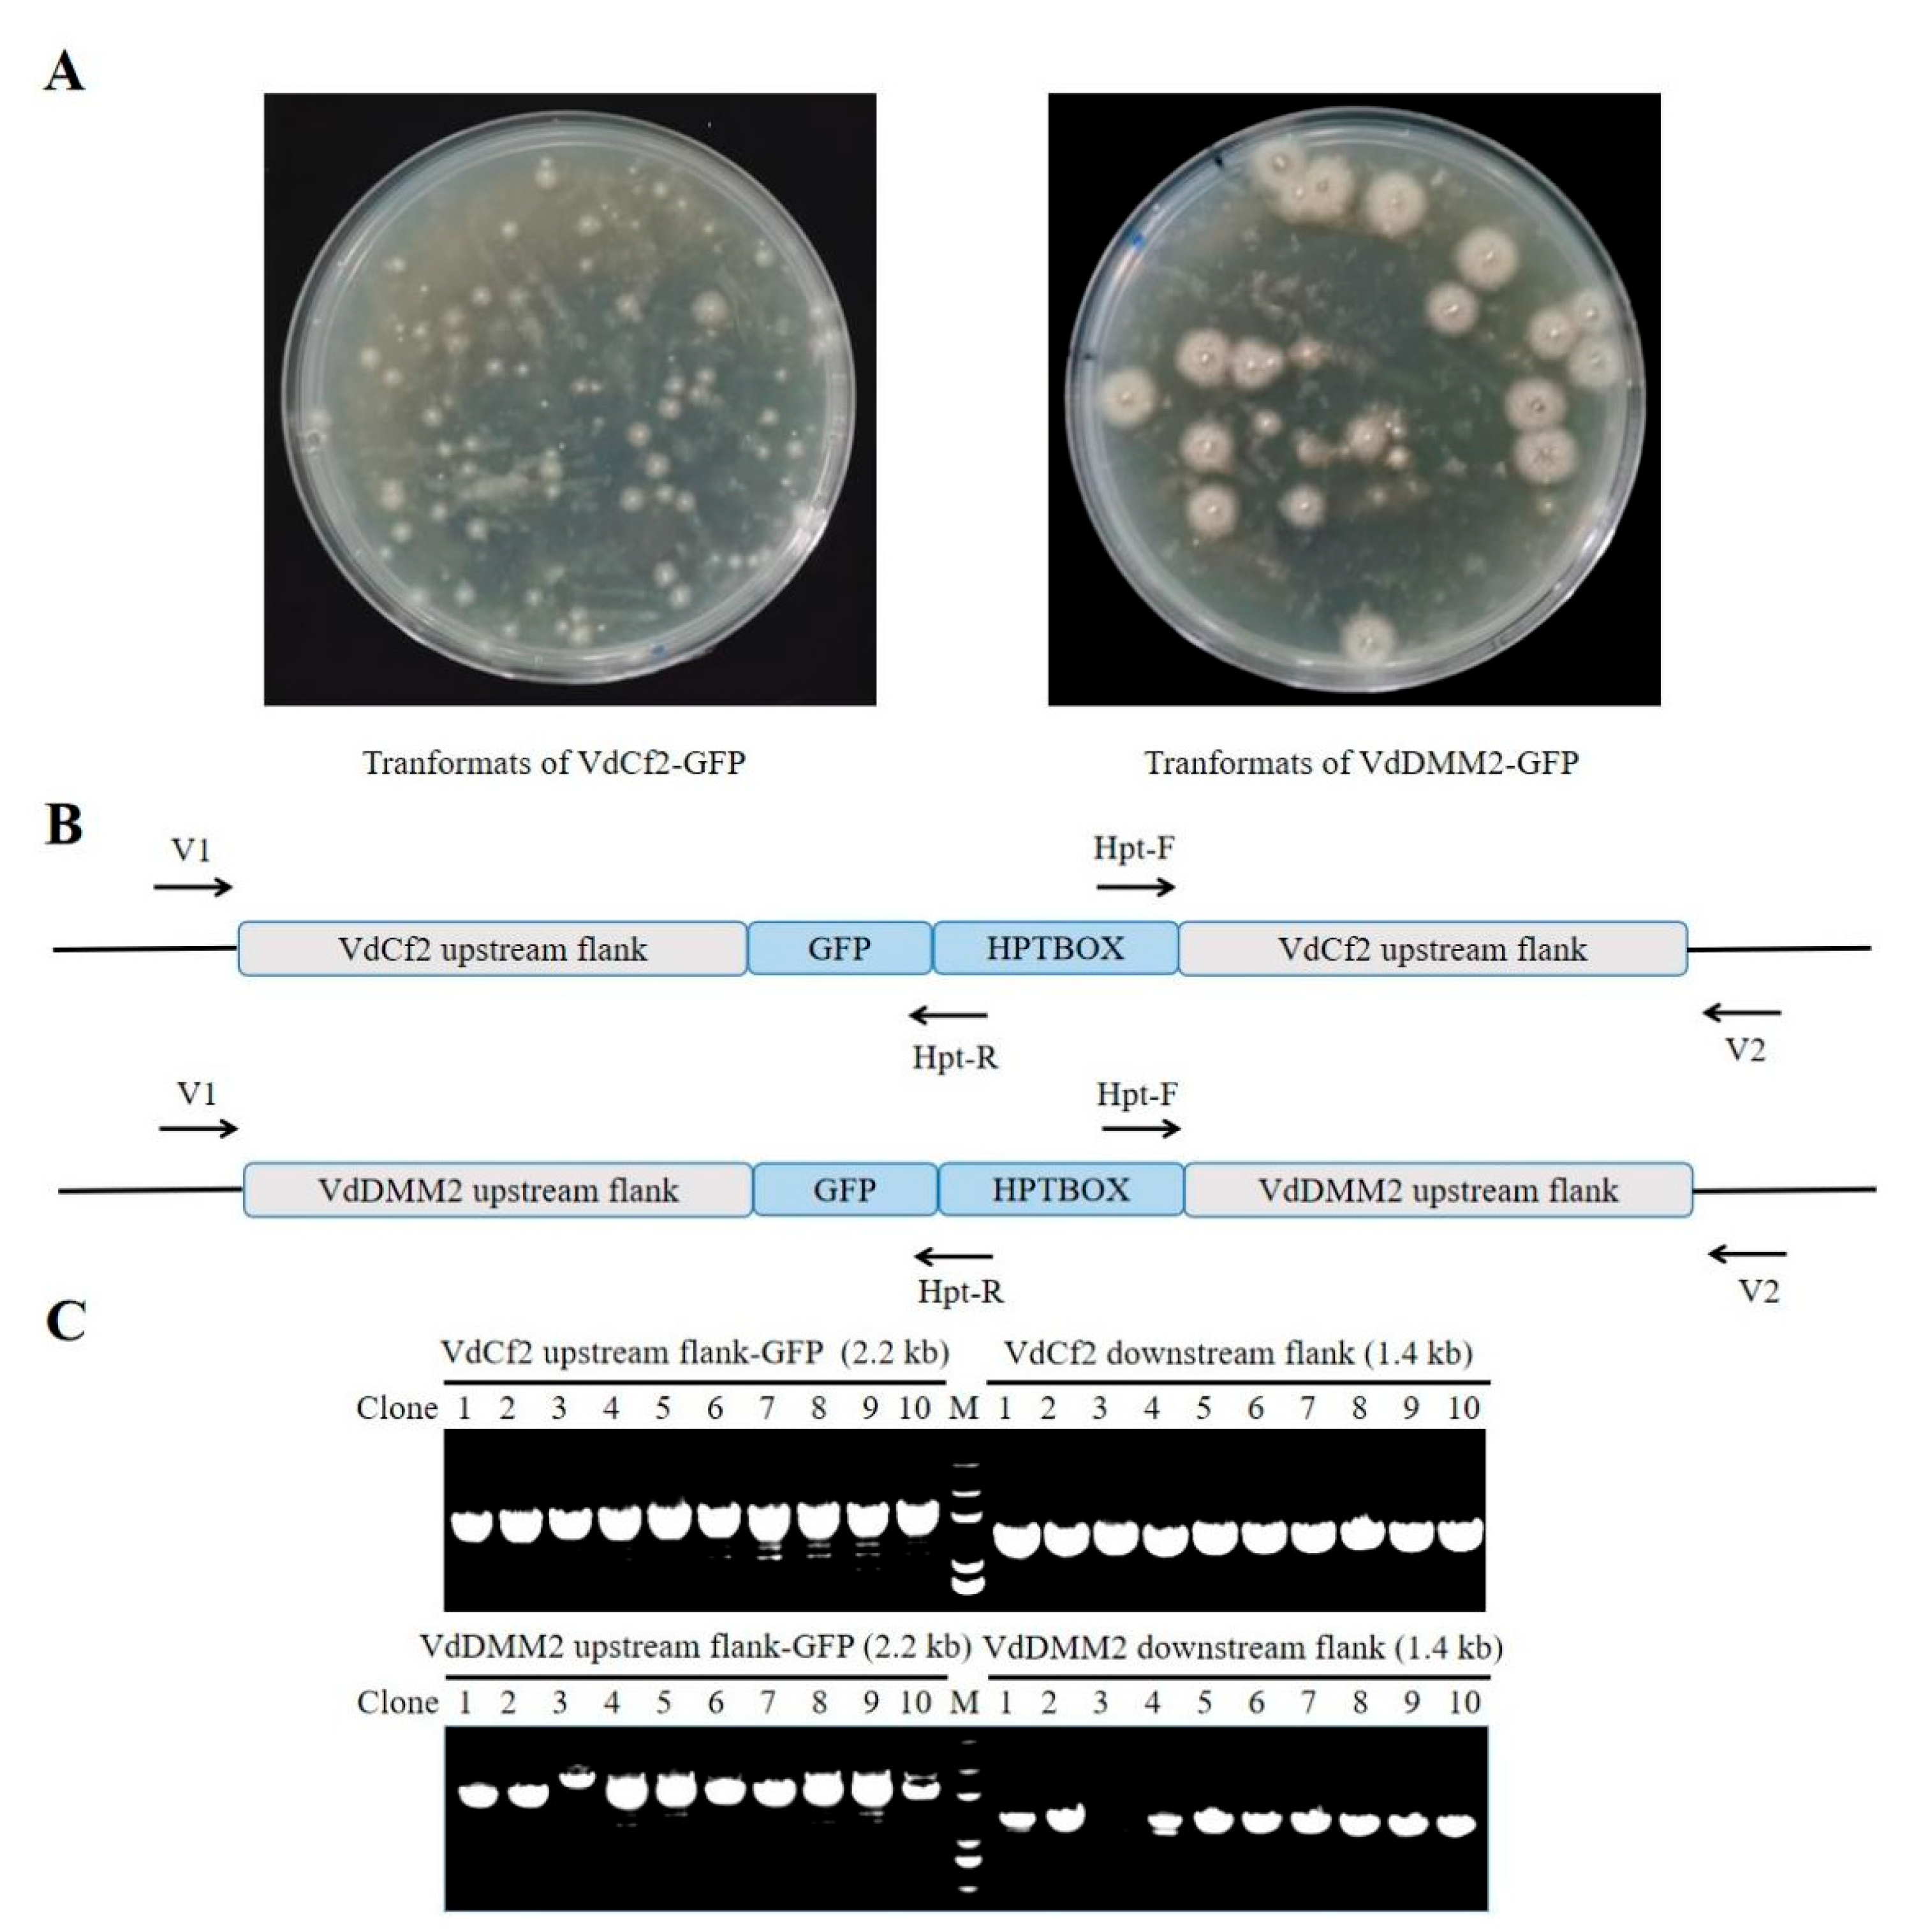
Preprints 93899 g003
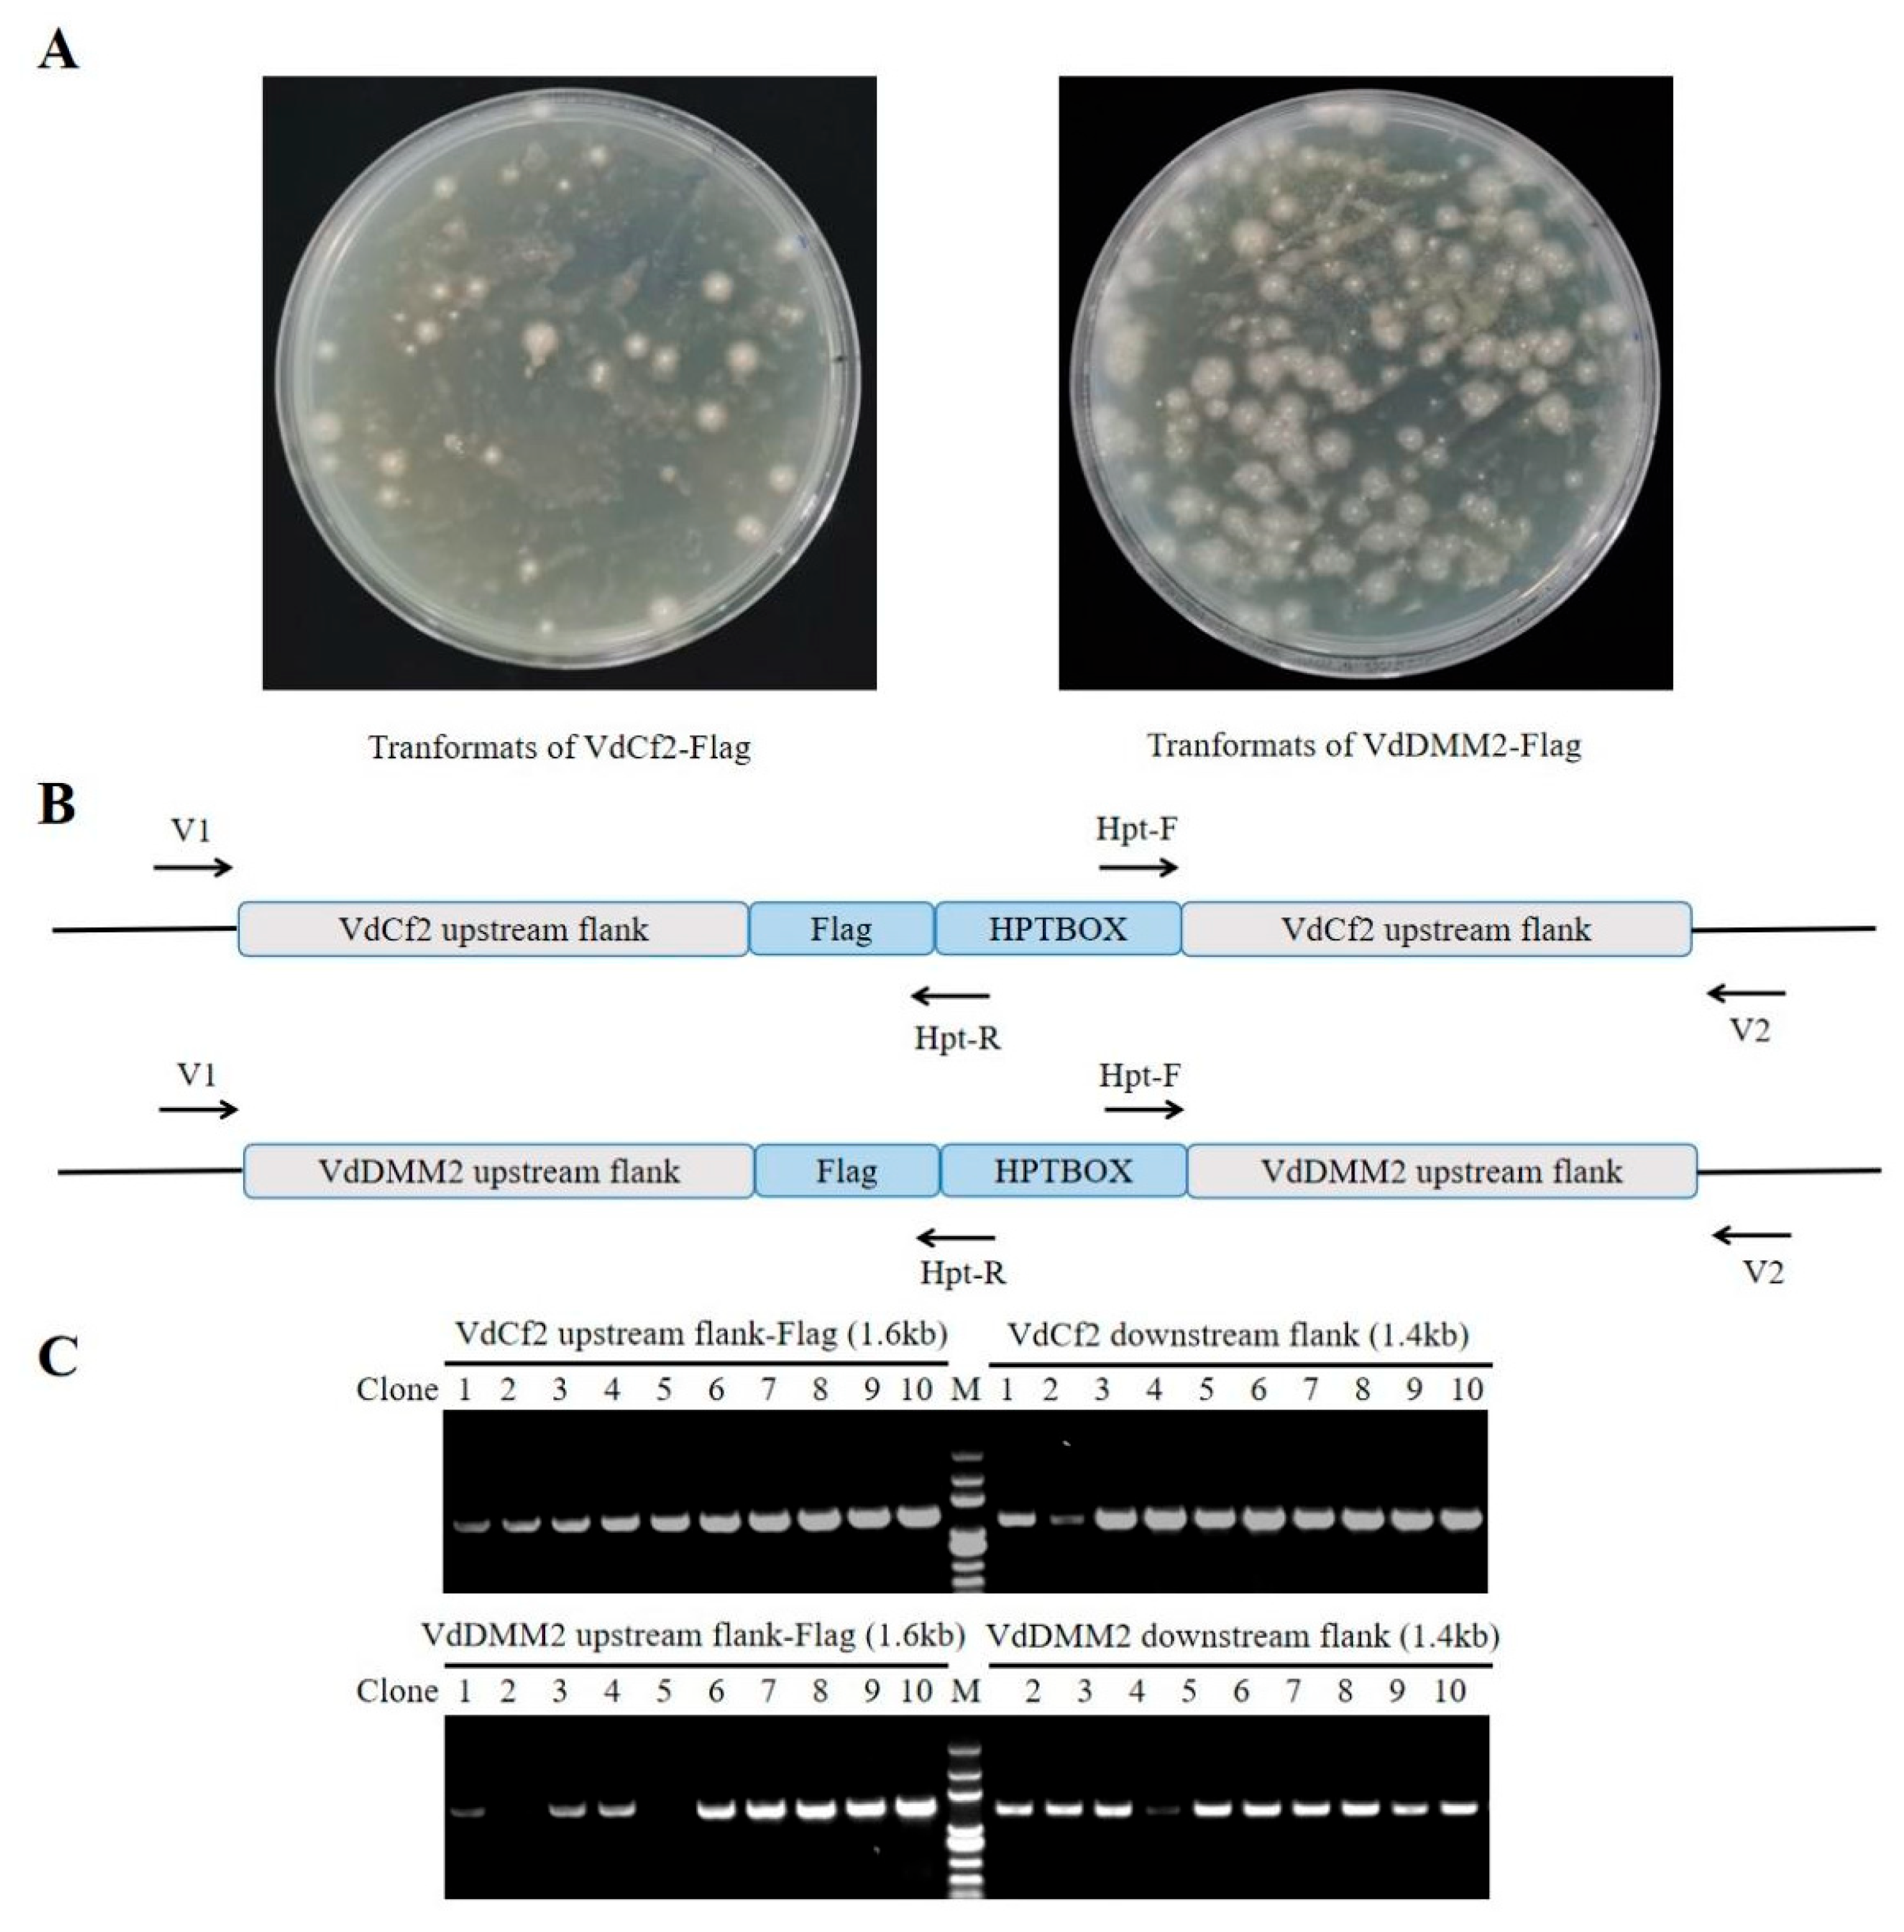
Preprints 93899 g005

1. INTRODUCTION
Verticillium dahliae, a soil-borne phytopathogen, is notorious for causing wilt disease across a wide range of plant species by colonizing their vascular systems, predominantly via root infection (Hu et al., 2017). This fungus is capable of producing microsclerotia, a type of dormant structure, enabling it to persist in soil for extended periods, even in the absence of a host plant. (Xie et al., 2017;Klosterman et al., 2009). Remarkably, V. dahliae can affect over 400 species of dicotyledonous plants, inclusive of vital crops such as cotton, tomato, potato, tobacco, and sunflower, which are all of high economic significance (Snelders et al., 2020; Chen et al., 2021; Wang et al., 2021). Among these, the impact of Verticillium wilt on cotton is particularly devastating, as it is the most destructive disease affecting this crop, causing substantial reductions in both yield and quality (Zhu et al., 2023). The control of V. dahliae presents increasing challenges due to its remarkable environmental adaptability, genetic variability, and intricate pathogenic mechanisms. Despite considerable efforts to elucidate the molecular mechanisms underlying V. dahliae's development and infection processes (Wen et al., 2023; Wu et al., 2023; Zhang et al., 2022; Sun et al., 2019), many of these aspects remain largely elusive. One possible reason for this challenge may be the limited availability of genetic manipulation tools available for this particular fungus, compared with other filamentous fungi.
Understanding the molecular basis of growth, development, and infection processes in plant pathogenic fungi, particularly through the functional analysis of key pathogenicity genes, is fundamental for enhancing crop resistance to fungal invasions (Song et al. 2020). Therefore, genome manipulation techniques that facilitate the direct modification or tagging of specific proteins, to study their functions within V. dahliae are recognized as potent tools for achieving this objective. However, current methods for protein labeling in V. dahliae often result in ex-situ manipulation or over-expression (Wen et al., 2023; Sun et al., 2019), which can lead to several adverse effects. Ectopic accumulation of tagged proteins beyond physiological levels may disrupt normal cellular function, induce negative feedback regulation, and may be toxic. Consequently, current protein tagging methods may not accurately represent the native structure or function of protein complexes, nor the true in vivo gene expression profiles in V. dahliae.
Homologous recombination offers a precise and efficient method for minimally invasive tagging at endogenous loci, as evidenced in various model organisms including Saccharomyces cerevisiae (Miao et al., 2023; Teubl et al., 2022; Kira et al., 2021; Khmelinskii et al., 2011; Sung et al., 2008), Drosophila (Kanca et al., 2022; Ghosh et al., 2018; Baena-Lopez et al., 2013), and others. This technique facilitates in vivo targeting and manipulation of genes on their normal chromosomal locations, and leads to the attachment of tags, such as fluorescent proteins or epitope tags, to these specific proteins. Tagged proteins enable the tracking of protein location within cells or tissues and the monitoring of protein expression and dynamics under native conditions in real-time, aiding in the visualization of their spatial distributions (Xiang et al., 2019; Khmelinskii et al., 2011). Furthermore, epitope tags (e.g., Flag or HA) can enhance the detection accuracy and purification efficiency of target proteins, and diminish the costs associated with synthesizing specific antibodies for different proteins (Shan et al., 2016; Shan et al., 2021). In V. dahliae, homologous recombination has been widely used for gene knockout, but the currently used protein labeling method often results from ex-situ or overexpression manipulation (Wang et al. 2016; Wen et al., 2023).
To address the challenges associated with elucidating the intrinsic characteristics of pathogenic proteins, and to facilitate more accurate biochemical and genetic studies in V. dahliae, we focus on the development of an efficient protein in situ tagging method in V. dahliae. We harnessed the endogenous homologous recombination machinery of V. dahliae to integrate specific tags at precise genomic loci, enabling the in situ C-terminal tagging of proteins of interest. This approach ensures the accurate placement of tags within the genome, thereby optimizing the fidelity of protein tagging.
To leverage the homologous recombination-based in situ tagging approach in V. dahliae, it is important to utilize a highly efficient transformation system, that can accurately introduce homologous DNA fragments into the host cells. A highly efficacious Agrobacterium tumefaciens-mediated transformation (ATMT) system for gene targeting in V. dahliae has been established (Wang et al., 2016), considering the critical role of ATMT in gene targeting across numerous filamentous fungi (Santhanam et al., 2012; Kramer et al., 2021). ATMT, an inherently biological process originally designed for transferring genes in plants, offers several distinct advantages over alternative methods, including (1) high transformation efficiency; (2) the capacity to introduce large DNA fragments with precision; and (3) the introduction of genes at a low copy number. Despite these benefits, ATMT is not without its limitations, which include: (1) occasional occurrences of multi-copy insertions; (2) a time-intensive transformation process; and (3) an inherently limited host range. To mitigate non-specific insertions during the transformation process, the implementation of the herpes simplex virus thymidine kinase (HSVtk) as a negative selection marker has been proposed, which has been shown to enhance the specificity of the transformation (Wang et al. 2016).
This study centered on two proteins: VdCf2 (VDAG-08721), which has been documented to localize to the nucleus (Liu et al., 2022), and another protein VdDMM2 (VDAG-00626), a candidate for nuclear localization. We developed an in situ tagging strategy to append GFP and Flag tags to the C-terminus of VdCf2 and VdDMM2, respectively, within the V. dahliae V592 strain. The resultant constructs, VdCf2-GFP, VdCf2-Flag, VdDMM2-GFP, and VdDMM2-Flag, were confirmed for genomic integration via PCR and sequencing. Confocal microscopy facilitated the visualization of the subcellular localization of the native GFP-tagged proteins, while the functionality of the Flag-tagged proteins was confirmed through Western blot analysis using anti-Flag antibodies, thus validating the efficacy of the in situ Flag-tagging approach.
2. MATERIALS and METHODS
2.1. Fungal and Bacterial Strains.
Verticillium dahliae strain V592, provided by Huishan Guo's Lab (isolated from cotton originating in Xinjiang, China, Gao et al., 2010),was the fungal specimen utilized in this study. Escherichia coli strain DH5α was employed for plasmid propagation. For fungal transformation, the Agrobacterium tumefaciens strain EHA105 was used. Transformants were incubated and selected on Potato Dextrose Agar (PDA) medium, supplemented with 5-fluoro-2’deoxyuridine (5FU) at a concentration of 20 µg/L and hygromycin B at 50 µg/ml. Competent cells of Escherichia coli DH5α and Agrobacterium tumefaciens EHA105 were sourced from Beijing Qingke Biological Company.
2.2. Vectors.
The foundational vector, pGKO-HPT, provided by Huishan Guo's Lab containing the herpes simplex virus thymidine kinase (HSVtk) negative selection marker, to inhibit ectopic integration and the hygromycin B resistance gene. GFP/Flag cassettes were PCR amplified from pHM1-GFP and pFA6a-3flag vector, respectively, and then cloned into the StuI-digested pGKO-HPT vector via homologous recombination, to generate the pGKO-tag-HPT vector for in situ tagging.
2.3. Construction and Transformation.
In situ tagging vectors were constructed by PCR-amplifying 1 kb upstream (5') and downstream (3') flanking sequences adjacent to the target protein's stop codon, excluding the stop codon itself. These sequences were then inserted into the PacI restriction cleavage sites flanking the tagging box (Flag or GFP) and the hygromycin resistance cassette within the pGKO-tag-HPT vector via homologous recombination. The completed in situ tagging vectors were then introduced into Agrobacterium strain EHA105 which was subsequently co-cultivated with the V. dahliae V592 strain. Transformants were selected on potato dextrose agar (PDA) plates supplemented with 5-fluoro-2’deoxyuridine (5FU) and hygromycin. Ultimately, the primer pairs V1/Hpt-R and V2/Hpt-F were used to PCR confirm the successful integration of tags for target proteins in V. dahliae transformants.
2.4. Confocal Laser Scanning Microscopy (CLSM).
V. dahliae conidia grown on Potato Dextrose Agar (PDA) medium were harvested and rinsed once with double distilled water (ddH2O), to remove any residual medium. A suitable volume of the conidial solution was placed on a silicified glass slide, air-dried, and then sealed with a DAPI dye solution. After a 10-minute incubation, samples were examined under a Leica TCS SP8 confocal microscope. GFP fluorescence was detected at an excitation wavelength of 488 nm, while DPAI-stained nuclei were visualized at 350 nm.
2.5. Protein Detection via Western Blotting.
Spores of V. dahliae were harvested and washed with PBS and then resuspended in 3ml of lysis buffer (50 mM Tris-HCl pH 7.4, 150 mM NaCl, 1mM EDTA, 1% Triton, 1×protease inhibitor cocktail). The cell suspension jelly was fast-frozen in liquid nitrogen and pulverized with a grinder (Xianfeng Scientific Instrument, 70 Hz, 1.5min, 3 times). The lysate was then diluted to 10 mL with lysis buffer and incubated with 150 μL Flag M2 agarose slurry (Sigma, A2220) at 4 ℃ overnight. The resin was washed three times with 1 mL TBS buffer each, and the tagged proteins were eluted with 100 μL 0.1M glycine-HCl (pH2.5) for 5-10min. The eluate was neutralized with 7.2 μL Tris-HCl (pH 8.0). Detection of VdCf2-Flag and VdDMM2-Flag was performed using Western blot analysis with anti-Flag antibodies (Sigma, F3165).
All primers used are listed in Supplementary Table S1.
3. RESULTS
3.1. The General Strategy for in situ C-terminusTagging in V. dahliae
To develop an
in situ tagging system for
V. dahliae via ATMT, our initial step was to engineer appropriate vectors. The foundational vector, pGKO-HPT, was equipped with a herpes simplex virus thymidine kinase (
HSVtk) negative-selection marker to curtail ectopic integration and confer hygromycin B resistance for selection. We modified this vector by inserting the desired tag upstream of the HPT gene
via homologous recombination, thus creating the pGKO-tag-HPT vector for protein tagging. Using this strategy, we synthesized the pGKO-Flag-HPT and pGKO-GFP-HPT vectors, containing the Flag and GFP tags, respectively (
Figure 1A).
To generate the
in situ tagging vector for a specific protein, we PCR-amplified the 1 kb upstream (5') and downstream (3') flanking sequences adjacent to the target protein's stop codon, excluding the stop codon itself, for insertion into the PacI restriction cutting sites flanking the tagging box (Flag or GFP) and the hygromycin resistance cassette within the pGKO-tag-HPT vector. To ensure proper orientation, the primers were designed to include the flanking 23bp homology sequence, with the PacI site sequence for both sides. The assembled
in situ tagging vectors were then introduced into
Agrobacterium strain EHA105. Following co-cultivation with the V592 strain cells of
V. dahliae, the positive transformants were selected on potato dextrose agar (PDA) plates supplemented with 5-fluoro-2’deoxyuridine (5FU) and hygromycin B (
Figure 1B). The ultimate result is the
in situ integration of the tag and the hygromycin-resistant cassette at the C-terminus of the target protein, mediated by
V. dahliae's intrinsic homologous recombination system (
Figure 1C).
3.2. In situ GFP Tagging of VdCf2 and VdDMM2 using pGKO-GFP-HPT vector
To assess the capability of the pGKO-GFP-HPT vector in mediating
in situ GFP tagging of specific proteins, we engineered the
in situ tagging constructs for
VdCf2 and
VdDMM2, incorporating the flanking sequences both upstream and downstream of the respective genes. Using
VdCf2 as a representative example, we commenced by synthesizing primer pairs VdCf2-G1 / VdCf2-G3 and VdCf2-G4 / VdCf2-G2 (Table S1) to PCR amplify the 5’ and 3’flanking regions respectively based on the reference genome sequence of
V. dahliae strain
VdLs.17 (Klosterman et al., 2011) (
Figure 2A ). The pGKO-GFP-HPT vector was subjected to PacI digestion to liberate the vector backbone along with the GFP-HPTBOX. Subsequent to this step, the amplified flanking sequences (
Figure 2 B) were seamlessly integrated into the PacI sites through homologous recombination, generating the pGKO-VdCf2-GFP-HPT construct (
Figure 2C). Verification of the construct was meticulously performed using PCR with the primer pairs pGKO-seq-F / Hpt-R and Hpt-F / pGKO-seq-R (
Figure 2C and Table S1). Upon confirmation, the resultant
in situ tagging vectors were finally introduced into
V. dahliae via ATMT, as described above. The methodology adopted for the construction of the
VdDMM2 in situ tagging vector mirrored that of
VdCf2, ensuring consistency in our approach.
3.3. Molecular Confirmation of C-terminal GFP Tagging for VdCf2 and VdDMM2 in V. dahliae
To confirm the successful
in situ GFP tagging of
VdCf2 transformants, we isolated the genomic DNA from the candidate transformants (
Figure 3A), and then designed the verification primer pair, to bind approximately 200 bp upstream of 5' flanking sequence (referred to as VdCf2-V1) and 200 bp downstream of 3' flanking sequence (referred to as VdCf2-V2) respectively. The primer pair VdCf2-V1 / Hpt-R was utilized to ascertain the insert of the correct upstream integration site, while the VdCf2-V2 / Hpt-F primer pair was applied for downstream validation (
Figure 3B and Table S1). The methodology adopted for the verification of the
VdDMM2 in situ GFP tagging was similar to
VdCf2. Our PCR verification results demonstrated a remarkably high efficiency of
in situ GFP tagging for
VdCf2 and
VdDMM2, with success rates of 100% and 90% respectively (
Figure 3C). To further validate the fidelity, sequencing of PCR products from the positive transformants was conducted, confirming the accurate integration of the
in situ GFP tags within the
VdCf2 and
VdDMM2 genes.
3.4. Subcellular-localization for in situ Tagged Endogenous VdCf2-GFP and VdDMM2-GFP in V. dahliae
To explore the subcellular localization of VdCf2-GFP and VdDMM2-GFP in
V. dahliae, we observed the
in situ tagged VdCf2-GFP and VdDMM2-GFP proteins within
V. dahliae cells using a confocal microscope (Leica TCS SP8). Previous studies have indicated nuclear localization for both proteins. Hence, we employed 4',6-diamidino-2-phenylindole (DAPI) staining to facilitate the identification of the nuclei in the cells. Confocal microscopy revealed distinct bright green foci within the positive transformants (
Figure 4), indicative of the successful GFP-tagging of the VdCf2 and VdDMM2 proteins. Notably, colocalization of the GFP fluorescence with the DAPI-stained nuclei was observed (
Figure 4), conclusively demonstrating that the endogenous VdCf2-GFP and VdDMM2-GFP fusion proteins indeed localized to the nucleus.
3.5. Assessment of Versatility for in in situ Tagging System within V. dahliae
To evaluate the broad applicability of our
in situ tagging strategy for the incorporation of various epitope tags into
V. dahliae proteins, we extended our approach to include the Flag epitope. Utilizing the pGKO-Flag-HPT vector, we performed
in situ Flag tagging for the
VdCf2 and
VdDMM2 genes, mirroring the methodology employed for GFP tagging. The procedure entailed the integration of upstream and downstream flanking sequences adjacent to the Flag tag and HPT selection marker, followed by transformation into
V. dahliae. To molecularly verify the transformants (
Figure 5A), we also designed the verification primers V1 and V2, which were paired with Hpt-R and Hpt-F respectively for PCR (
Figure 5B and Table S1). And the products were then sequenced for further verification. The efficiency of generating VdCf2-Flag and VdDMM2-Flag tagged strains was still impressively high, with success rates of 100% and 80% , respectively (
Figure 5C).
3.6. Validation of Endogenous VdCf2-Flag and VdDMM2-Flag Fusion Proteins in V. dahliae by Western Blot Analysis
To confirm the in vivo expression of Flag-tagged VdCf2 and VdDMM2 fusion proteins in V. dahliae, we isolated proteins from positive transformants expressing VdCf2-Flag and VdDMM2-Flag, using anti-Flag agarose beads (Sigma, A2220). Subsequent Western blot analysis was conducted utilizing an anti-Flag antibody (Sigma, F3165), to detect the presence of the fusion proteins. The resulting immunoblots revealed distinct bands corresponding to VdCf2-Flag and VdDMM2-Flag, thereby verifying their successful expression in the transformants. In contrast, no such bands were detected in the wild-type strain, confirming the specificity of the Flag-tagging and the absence of endogenous Flag-tagged proteins.
Figure 6.
Western Blot Analysis of VdCf2 and VdDMM2 in situ Flag tagging in V. dahliae. (A)Western blot confirmation of VdCf2-Flag protein expression, with total protein loading visualized by Coomassie brilliant blue (CBB) staining. (B) Western blot confirmation of VdDMM2-Flag protein expression, with total protein loading visualized by CBB staining.
Figure 6.
Western Blot Analysis of VdCf2 and VdDMM2 in situ Flag tagging in V. dahliae. (A)Western blot confirmation of VdCf2-Flag protein expression, with total protein loading visualized by Coomassie brilliant blue (CBB) staining. (B) Western blot confirmation of VdDMM2-Flag protein expression, with total protein loading visualized by CBB staining.
4. DISCUSSION
The soilborne fungal pathogen V. dahliae presents a significant challenge to agriculture due to its high virulence, broad host range, and the difficulty associated with its management. In recent years, Host-induced gene silencing (HIGS), a technique derived from trans-kingdom RNA interference (RNAi), has emerged as an innovative strategy for the mitigation of V. dahliae infections (Hua et al., 2018). This approach hinges on the identification and utilization of fungal genes that are pivotal for its growth and pathogenicity, underscoring the importance of functional genomics in the control of this pathogen.
Protein tagging is a cornerstone in the elucidation in the study of gene function and localization. Currently, A suite of gene tagging methodologies has been developed and refined, including homologous recombination (Davidson et al., 2002), transposon tagging (Vandenbussche et al., 2013), CRISPR/Cas9-mediated endogenous gene tagging (Wang et al., 2019) and epitope tagging (Barnard et al., 2008), each contributing valuable insights into fungal studies.
In the study of gene function within fungal systems, ectopic expression has been proven invaluable. For example, in Saccharomyces cerevisiae, researchers have extensively utilized the Yeast two-hybrid system for ectopic protein tagging, to decipher protein interactions. Following advances include the epitope tagging of each protein's open reading frame (ORF), facilitating the construction of a comprehensive library of hybrid proteins, to dissect protein-protein interactions (Uetz et al., 2000). While gene localization studies have predominantly relied on overexpression systems to yield more robust signals (Wu et al., 2023; Wen et al., 2023), the use of ectopic or overexpression tags is not without its detriments. Such approaches can inadvertently alter the native expression levels and functionality of the protein, disrupt complex assembly, lead to gene silencing, or even result in lethality of the cells. Therefore, the pursuit of more refined gene tagging methods that preserve the endogenous context of target genes, remains a critical objective for the accurate interpretation of protein function and interaction networks within V. dahliae.
In contrast to ectopic or overexpression of proteins, in situ tagging offers a methodological advantage by maintaining the native levels of endogenous proteins. This method has been successfully implemented in various model fungal organisms, including Saccharomyces cerevisiae and Schizosaccharomyces pombe (Miao et al., 2023; Khmelinskii et al., 2011; Shan et al., 2016; Shan et al., 2021), setting a precedent for its application in fungal study. Despite its proven efficacy in model systems, the adoption of in situ tagging system in plant pathogenic fungi, particularly in V. dahliae, remains scant. This situation significantly constrains our capacity to study the structural, functional, and physiological aspects of this pathogen. The integration of in situ tagging methods into the research toolkit for these filamentous pathogen fungi represents a formidable approach to elucidate the localization, interactions, and dynamic behavior of intracellular molecules. Its application is poised to yield new insights into the cellular biology of V. dahliae, thereby advancing our understanding of its pathogenic mechanisms and informing the development of novel control strategies.
In this study, we validated the effectiveness of the homologous recombination-based in situ tagging method in the filamentous pathogen fungus V. dahliae V592, exemplified by the successful tagging of VdCf2 and VdDMM2 with Flag and GFP, respectively. After in situ tagging, the resultant fusion proteins were expressed at normal levels within V. dahliae, and their intracellular localization was consistent with previously reported observations. The application of Flag tagging, possibly followed by affinity purification and mass spectrometry analysis, has set the stage for probing the interacting partners of these proteins, thereby facilitating a deeper understanding of protein complexes, which is a pivotal aspect of functional proteomics. Moreover, this methodology is not confined to Flag or GFP tags. It also enables the integration of alternative tags or inducible promoters into V. dahliae via homologous recombination. This advancement is particularly useful as it provides a strategy to surmount the inherent autofluorescence often encountered in fungal cells, and it paves the way for the regulable expression of target proteins.
Looking ahead, future work should concentrate on enhancing the efficiency of transformation techniques, given the intricacy and laborious nature of ATMT for V. dahliae. Additionally, the expansion of the tagging types is imperative to fully harness the capabilities of this method and to propel the functional genomics of V. dahliae, or other plant pathogens into new frontiers.
Author Contributions
J.Y.: methodology; investigation; data curation; formal analysis; writing—original draft; writing—review and editing.; M.L.: methodology; investigation; data curation; formal analysis; writing—original draft; writing—review and editing.; Y.J.: resources; investigation; data curation. ; H-S.G.: supervision; funding acquisition; resources; writing—review and editing.; C-M.S.: Conceptualization; supervision; funding acquisition; methodology; resources; writing—original draft; writing—review and editing.; H.W.: Conceptualization; supervision; project administration; methodology; resources; investigation; data curation; writing—original draft; writing—review and editing.
Acknowledgments
We thank Jian-Hua Zhao, Bo-Sen Zhang, and Yun Jin for their assistance in establishing the experimental and technical framework necessary for the study on Verticillium dahliae. We thank Li Wang for providing pHM1-GFP vector. The work was supported by the Chinese Academy of Sciences (CAS) Projects for Young Scientists in Basic Research (YSBR-080 to C-M.S.). The funder has not played any role in the study design, data collection and analysis, decision to publish, or preparation of the manuscript.
Conflicts of Interest
The authors declare that there is no conflict of interest.
References
- Baena-Lopez LA, Alexandre C, Mitchell A, Pasakarnis L, Vincent JP. Accelerated homologous recombination and subsequent genome modification in Drosophila. Development. 2013;140(23):4818-4825. [CrossRef]
- Barnard E, McFerran NV, Trudgett A, Nelson J, Timson DJ. Detection and localisation of protein-protein interactions in Saccharomyces cerevisiae using a split-GFP method. Fungal Genet Biol. 2008 May;45(5):597-604. Epub 2008 Jan 26. PMID: 18313953. [CrossRef]
- Chen JY, Zhang DD, Huang JQ, et al. Dynamics of Verticillium dahliae race 1 population under managed agricultural ecosystems[J]. BMC Biology, 2021, 19(1).
- Davidson RC, Blankenship JR, Kraus PR, de Jesus Berrios M, Hull CM, D'Souza C, Wang P, Heitman J. A PCR-based strategy to generate integrative targeting alleles with large regions of homology. Microbiology (Reading). 2002 Aug;148(Pt 8):2607-2615. PMID: 12177355. [CrossRef]
- Gao F, Zhou BJ, Li GY, et al. A glutamic acid-rich protein identified in Verticillium dahliae from an insertional mutagenesis affects microsclerotial formation and pathogenicity. PLoS One. 2010;5(12):e15319. Published 2010 Dec 7. [CrossRef]
- Ghosh S, Liu JL. Genomic Tagging of AGO1 Using CRISPR/Cas9-Mediated Homologous Recombination. Methods Mol Biol. 2018;1680:217-235. [CrossRef]
- Hu, XP, Gurung, S, Short, DPG, et al. Nondefoliating and Defoliating Strains from Cotton Correlate with Races 1 and 2 of Verticillium dahliae[J]. Plant Disease, 2017, 101(7): 1338.
- Hua C, Zhao JH, Guo HS. Trans-Kingdom RNA Silencing in Plant-Fungal Pathogen Interactions. Mol Plant. 2018;11(2):235-244. [CrossRef]
- Kanca O, Zirin J, Hu Y, et al. An expanded toolkit for Drosophila gene tagging using synthesized homology donor constructs for CRISPR-mediated homologous recombination. Elife. 2022;11:e76077. Published 2022 Jun 20. [CrossRef]
- Khmelinskii A, Meurer M, Duishoev N, Delhomme N, Knop M. Seamless gene tagging by endonuclease-driven homologous recombination. PLoS One. 2011;6(8):e23794. [CrossRef]
- Kira S, Noda T. A CRISPR/Cas9-based method for seamless N-terminal protein tagging in Saccharomyces cerevisiae. Yeast. 2021;38(11):592-600. [CrossRef]
- Klosterman SJ, Atallah ZK, Vallad GE, Subbarao KV. Diversity, pathogenicity, and management of verticillium species. Annu Rev Phytopathol. 2009;47:39-62. PMID: 19385730. [CrossRef]
- Klosterman, S. J., Subbarao, K. V., Kang, S., Veronese, P., Gold, S. E., Thomma, B. P., Chen, Z., Henrissat, B., Lee, Y. H., Park, J., Garcia-Pedrajas, M. D., Barbara, D. J., Anchieta, A., de Jonge, R., Santhanam, P., Maruthachalam, K., Atallah, Z., Amyotte, S. G., Paz, Z., Inderbitzin, P., … Ma, L. J. (2011). Comparative genomics yields insights into niche adaptation of plant vascular wilt pathogens. PLoS pathogens, 7(7), e1002137. [CrossRef]
- Kramer HM, Cook DE, van den Berg GCM, Seidl MF, Thomma BPHJ. Three putative DNA methyltransferases of Verticillium dahliae differentially contribute to DNA methylation that is dispensable for growth, development and virulence. Epigenetics Chromatin. 2021;14(1):21. Published 2021 May 3. [CrossRef]
- Liu T, Qin J, Cao Y, et al. Transcription Factor VdCf2 Regulates Growth, Pathogenicity, and the Expression of a Putative Secondary Metabolism Gene Cluster in Verticillium dahliae. Appl Environ Microbiol. 2022;88(22):e0138522. [CrossRef]
- Miao Z, Wang H, Tu X, et al. GetPrimers: A generalized PCR-based genetic targeting primer designer enabling easy and standardized targeted gene modification across multiple systems. Yeast. Published online December 2, 2023. [CrossRef]
- Santhanam P. Random insertional mutagenesis in fungal genomes to identify virulence factors. Methods Mol Biol. 2012;835:509-17. PMID: 22183674. [CrossRef]
- Shan CM, Kim JK, Wang J, Bao K, Sun Y, Chen H, Yue JX, Stirpe A, Zhang Z, Lu C, Schalch T, Liti G, Nagy PL, Tong L, Qiao F, Jia S. The histone H3K9M mutation synergizes with H3K14 ubiquitylation to selectively sequester histone H3K9 methyltransferase Clr4 at heterochromatin. Cell Rep. 2021 May 18;35(7):109137. PMID: 34010645; PMCID: PMC8167812 . [CrossRef]
- Shan CM, Wang J, Xu K, et al. A histone H3K9M mutation traps histone methyltransferase Clr4 to prevent heterochromatin spreading. Elife. 2016;5:e17903. Published 2016 Sep 20. [CrossRef]
- Snelders NC, Rovenich H, Petti GC, et al. Microbiome manipulation by a soil-borne fungal plant pathogen using effector proteins[J]. Nature Plants, 2020, 6(11):1-10.
- Song R, Li J, Xie C, Jian W, Yang X. An Overview of the Molecular Genetics of Plant Resistance to the Verticillium Wilt Pathogen Verticillium dahliae. Int J Mol Sci. 2020 Feb 7;21(3):1120. PMID: 32046212; PMCID: PMC7037454. [CrossRef]
- Sun L, Qin J, Rong W, Ni H, Guo HS, Zhang J. Cellophane surface-induced gene, VdCSIN1, regulates hyphopodium formation and pathogenesis via cAMP-mediated signalling in Verticillium dahliae. Mol Plant Pathol. 2019;20(3):323-333. [CrossRef]
- Sung MK, Ha CW, Huh WK. A vector system for efficient and economical switching of C-terminal epitope tags in Saccharomyces cerevisiae. Yeast. 2008 Apr;25(4):301-11. PMID: 18350525. [CrossRef]
- Teubl F, Schwank K, Ohmayer U, Griesenbeck J, Tschochner H, Milkereit P. Tethered MNase Structure Probing as Versatile Technique for Analyzing RNPs Using Tagging Cassettes for Homologous Recombination in Saccharomyces cerevisiae. Methods Mol Biol. 2022;2533:127-145. [CrossRef]
- Uetz P, Giot L, Cagney G, et al. A comprehensive analysis of protein-protein interactions in Saccharomyces cerevisiae. Nature. 2000;403(6770):623-627. [CrossRef]
- Vandenbussche M, Zethof J, Gerats T. Transposon display: a versatile method for transposon tagging. Methods Mol Biol. 2013;1057:239-50. PMID: 23918433. [CrossRef]
- Wang D, Chen JY, Song J, Li JJ, Klosterman SJ, Li R, Kong ZQ, Subbarao KV, Dai XF, Zhang DD. Cytotoxic function of xylanase VdXyn4 in the plant vascular wilt pathogen Verticillium dahliae. Plant Physiol. 2021 Sep 4;187(1):409-429.
- Wang Q, Coleman JJ. CRISPR/Cas9-mediated endogenous gene tagging in Fusarium oxysporum. Fungal Genet Biol. 2019;126:17-24. [CrossRef]
- Wang S, Xing H, Hua C, Guo HS, Zhang J. An Improved Single-Step Cloning Strategy Simplifies the Agrobacterium tumefaciens-Mediated Transformation (ATMT)-Based Gene-Disruption Method for Verticillium dahliae. Phytopathology. 2016 Jun;106(6):645-52. Epub 2016 Mar 30. PMID: 26780432. [CrossRef]
- Wen HG, Zhao JH, Zhang BS, et al. Microbe-induced gene silencing boosts crop protection against soil-borne fungal pathogens. Nat Plants. 2023;9(9):1409-1418. [CrossRef]
- Wu XM, Zhang BS, Zhao YL, et al. DeSUMOylation of a Verticillium dahliae enolase facilitates virulence by derepressing the expression of the effector VdSCP8. Nat Commun. 2023;14(1):4844. Published 2023 Aug 10. [CrossRef]
- Xiang X, Li C, Chen X, et al. CRISPR/Cas9-Mediated Gene Tagging: A Step-by-Step Protocol. Methods Mol Biol. 2019;1961:255-269. [CrossRef]
- Xie C, Li Q, Yang X. Characterization of VdASP F2 Secretory Factor from Verticillium dahliae by a Fast and Easy Gene Knockout System. Mol Plant Microbe Interact. 2017 Jun;30(6):444-454. Epub 2017 May 8. PMID: 28291379. [CrossRef]
- Zhang BS, Li YC, Guo HS, Zhao JH. Verticillium dahliae Secretes Small RNA to Target Host MIR157d and Retard Plant Floral Transition During Infection. Front Plant Sci. 2022;13:847086. Published 2022 Apr 18. [CrossRef]
- Zhu Y, Zhao M, Li T, Wang L, Liao C, Liu D, Zhang H, Zhao Y, Liu L, Ge X, Li B. Interactions between Verticillium dahliae and cotton: pathogenic mechanism and cotton resistance mechanism to Verticillium wilt. Front Plant Sci. 2023 Apr 21;14:1174281. PMID: 37152175; PMCID: PMC10161258 . [CrossRef]
|
Disclaimer/Publisher’s Note: The statements, opinions and data contained in all publications are solely those of the individual author(s) and contributor(s) and not of MDPI and/or the editor(s). MDPI and/or the editor(s) disclaim responsibility for any injury to people or property resulting from any ideas, methods, instructions or products referred to in the content. |
© 2023 by the authors. Licensee MDPI, Basel, Switzerland. This article is an open access article distributed under the terms and conditions of the Creative Commons Attribution (CC BY) license (http://creativecommons.org/licenses/by/4.0/).